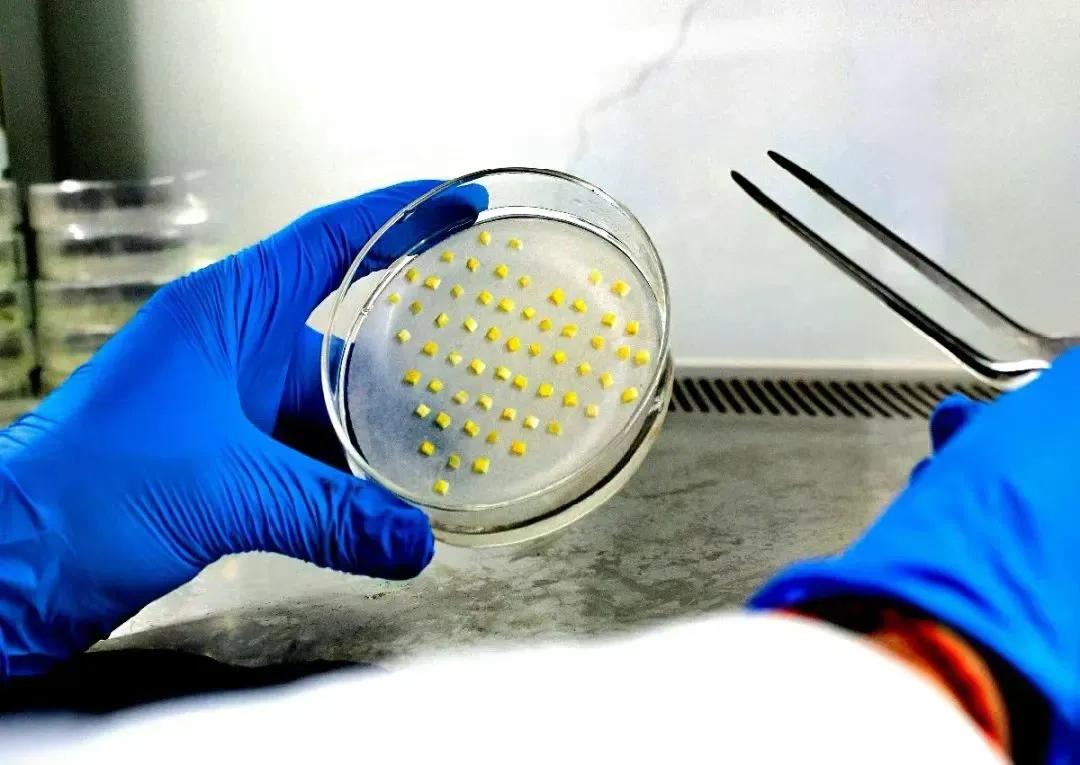

西北农林科技大学园艺2104班逆袭记:25人班级76%升学率,3人保研16人考研成功
西北农林科技大学园艺2104班逆袭记:25人班级76%升学率,3人保研16人考研成功
西北农林科技大学园艺学院2104班刚开始并不理想。在2025届毕业季来临之前,这个由25名学生组成的班级,因为挂科率高、奖学金名额少,被称作“普通”。学生们在学习上遇到了困难,外界也有不少质疑,然而他们并未意识到,成功正在慢慢萌芽。三人成功获得保研机会,十六人考研成功,整个班级的升学率高达七十六个百分点。西北农林科技大学园艺学院2104班的故事令人瞩目,你可能会好奇,是什么因素让他们取得了如此成就?

困境起步
西北农林科技大学园艺学院2104班刚开始并不理想。在2025届毕业季来临之前,这个由25名学生组成的班级,因为挂科率高、奖学金名额少,被称作“普通”。学生们在学习上遇到了困难,外界也有不少质疑,然而他们并未意识到,成功正在慢慢萌芽。那时的班级宛如一块未被开发的土地,既充满挑战,又孕育着无限的可能。
惊人逆袭
谁能料到,这个原本普通的班级竟实现了惊人的转变。在2025届的毕业季,他们呈现了一份让人赞叹的成绩单。三人成功获得保研机会,十六人考研成功,整个班级的升学率高达七十六个百分点。他们纷纷被浙江大学、中国农业大学、上海交通大学等知名学府录取。这样的成就,犹如一颗重磅炸弹,在校内引发了巨大的关注。
同窗互助

班级里形成了积极的学习环境,建立了学习团队。陈同学,他以348分成绩考入西北农林科技大学,对此深有体会,他提到晚上在实验室总能找到同伴。此外,班级里还自主成立了跨专业的科研团队,传承和帮助他人。保研的三人小组整理了高频考点,与大家共享考研资料,用实际行动践行着“不让任何一个同学掉队”的承诺。
学院理念
园艺学院始终坚持“以学生为中心”的原则,充分尊重学生的独特个性,接纳他们各自的成长道路,并全力促进他们的个人成长。基于此,学院制定了“定制化培养计划、灵活的发展模式、资源倾斜支持”的培养策略。为学术导向的学生配备科研指导老师,为实践导向的学生搭建产业实践平台,同时激励学生拓宽视野,提升能力。这些措施为学生成长提供了坚实的保障。
培养模式
学院实施了本科到硕士再到博士的连贯培养体系,确保所有本科生都能参与到科创项目中来。我们鼓励学生尽早加入课题组,尽早投身研究,并尽早产出高质量的科研成果。借助各个研究团队和园艺科学研究中心等科研设施,本科生有机会在科研前沿实现突破,增强个人竞争力。这种培养方式为学生的科研生涯奠定了坚实的基础。

学子志向

2025届的毕业生们展现出强烈的志向。在17名考研学生中,有15人决定留在农业领域,他们共同誓言:“要让国产蔬菜搭载‘中国心’。”园艺学院把专业课程搬到了田间地头,打造了“榜样、项目、平台”三位一体的培养模式。借助这些支持系统,学院培育出了将论文与祖国大地紧密结合的新时代农业人才。
西北农林科技大学园艺学院2104班的故事令人瞩目,你可能会好奇,是什么因素让他们取得了如此成就?欢迎在评论区发表你的见解。同时,别忘了点赞并转发这篇文章!
